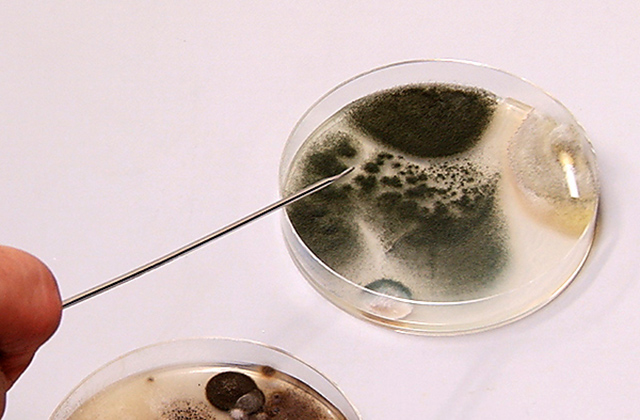

エアコンのお掃除
カビ専門家に聞く!エアコンをつけると咳やくしゃみが出るのはなぜ!?
久しぶりにエアコンをつけると、なぜか咳やくしゃみが止まらないということはありませんか?
その原因を探るため、ひとに病気を起こすカビやその毒性などを研究している、千葉大学 真菌医学研究センター 准教授の矢口貴志先生におそうじ本舗の研究員がインタビューをしました。菌とカビを研究して30年以上、テレビでも引っ張りだこの“カビ博士”です。

目 次
家に生える「危険なカビ」があるって本当?
研究員:一般の住宅に発生するカビの中で、放っておくと危険なカビがあるというのは本当ですか?
矢口先生:はい。特にアスペルギルス・フミガータスというカビは、一番ひとに対して感染力の強いカビといわれています。
エアコンから採取したカビを培養して解説

矢口先生:このカビが、そのアスペルギルス・フミガータスです。
矢口先生:アスペルギルス・フミガータスは、空気が淀んでいるエアコンや部屋の中にある乾いたホコリの中にも生息しており、一般的にどの家庭でもいるカビです。
研究員:ぞっとしますね……。危険なカビということですが、ひとの身体にどんな影響があるんですか?
矢口先生:最初に考えられるのが呼吸器系のアレルギーです。免疫の落ちた方に対しては、呼吸器系にカビが感染してしまう場合があります。特に、免疫力の低い子どもや高齢者の方、肺炎やがんを患わっている方、アレルギーをお持ちの方、そのほか臓器移植の予定やアトピーなどで免疫抑制剤を飲んでいる方は注意が必要です。
エアコンのカビを防ぐにはどうしたらいい?
研究員:カビを防ぐ方法はありますか?
矢口先生:カビを完全に予防するということは不可能ですが、エアコンで冷房を使用した後にはエアコン内部をよく乾燥させることと、あとはフィルターなどの掃除をまめにすると、カビの繁殖を抑制することができます。
フィルター掃除は2週間に1回くらい。内部の乾燥はできれば使用した後に毎日行っていただきたいのですが、なかなかできないと思いますので、2~3日に1度送風運転でエアコン内部を乾かしてやることが必要となります。

カビが繁殖しやすい条件は、温度が20℃~30℃、湿度が60%を超える時期ですので、梅雨時はもちろんですが、9月~10月にかけての雨の多い時期にも注意が必要ですね。
エアコンをつけたら…咳やくしゃみが出る!
研究員:蒸し暑くなってきて、今シーズン初めてエアコンをつけたら、咳とくしゃみが止まらないんです!フィルターはたまに掃除しているのですが……。
矢口先生:それはカビが原因の可能性があります。エアコンの中にはかなり水分がありますので、カビは生えやすくなります。またフィルターもホコリがたまりますと、そこでカビは繁殖します。
そして、カビの胞子はホコリに付着してエアコンの吹き出し口から飛散します。一般的には、エアコンを10分つけると1,000個ぐらいのカビの胞子が吹き出すといわれています。

※微粒子を可視化する特殊なライトを使用して撮影
研究員:1,000個のカビ胞子!?カビが生えてしまった場合、どうしたらいいですか?
矢口先生:普段は、エアコンフィルターをこまめに掃除して予防しましょう。エアコン内部にカビが発生してしまったら、専門の業者に洗浄をお願いするのがいいと思います。

カビ博士からアドバイス
矢口先生:私たちの生活環境の中から、カビをゼロにすることは基本的に無理です。我々はカビを吸うと、アレルギーなどの疾患になることがあるので、なるべくカビを吸わないようにする必要があります。カビはホコリと一緒に家の中に入ってきますので、なるべくホコリが入らないように気を付けましょう。
カビを予防するには、カビの生える条件である、温度・湿度・栄養源を取り除くことが必要になります。湿度を下げるには、換気が一番効果がありますし、カビはあらゆるものを栄養源としますので、ホコリをはじめとした汚れを取り除く掃除が必要になります。これらのことを注意して生活すれば、我々はあまりカビと接しない生活ができると思います。
研究員:カビ博士、ありがとうございました!
【まとめ】エアコンのカビを予防する方法

私たちが生活するうえで欠かせないエアコンは、カビが生えやすい環境であることがわかりました。
また、カビ博士によると「カビは呼吸器系のアレルギーを引き起こす可能性がある」ということでしたので、エアコンのカビには注意が必要です。
では、具体的にはどのようにエアコンのカビを予防したらよいのでしょうか。
以下にエアコンのカビ予防をまとめました。
カビ予防①エアコンを掃除する
エアコン内部でカビが繁殖するのを防ぐためには、フィルターを定期的に掃除してホコリを取り除くことが重要です。
フィルターの掃除
エアコンは室内の空気を吸い込む際、空気中のホコリやチリがエアコン内部に入り込まないようにするため、ホコリやチリをキャッチするフィルターが設置されています。そのため、フィルターにはホコリなどの汚れがたまりやすいのです。
2週間に1回程度、フィルターの掃除を行いましょう。
フィルターを取り外して表側から掃除機をかけるだけでもホコリを取り除けます。
編み目にホコリが詰まっている場合は、裏側からシャワーをかけると、キレイにホコリを取り除けます。その後、表側からもシャワーをかけて汚れを洗い流します。
洗った後は水分を拭き取り、陰干しして乾かしましょう。水分が残っていると、カビの原因になることがあるので、完全に乾かしてから元に戻します。
また、お掃除機能付きエアコンの場合は、フィルターの掃除を自動で行ってくれますが、ダストボックスにはフィルターから集めたホコリなどのゴミが溜まるので、ダストボックスのゴミを定期的に捨てましょう。
エアコン本体の外側の掃除
エアコン本体の外側に付着したホコリなどの汚れも、定期的に掃除して取り除きましょう。
特にエアコン上部はホコリが溜まりやすい部分です。タオルやハンディモップなどを使って、ホコリを取り除いてください。
合わせて読もう:エアコンのフィルターを掃除するメリットと効果的な掃除方法
エアコン内部の掃除は業者へ依頼
エアコン内部を掃除するには、エアコンの構造を理解している必要があります。
精密機械であるエアコンを自分で掃除しようとすると、手間がかかるうえに故障などのリスクも大きくなります。
ご家庭では掃除が難しいエアコン内部の掃除は、専門の業者にエアコンクリーニングを依頼しましょう。
カビ予防②冷房・除湿運転後はエアコン内部を乾燥させる
冷房・除湿運転中はエアコンで冷やした空気と外気温の温度差により、エアコン内部で結露水が発生して湿度が高い状態になります。
カビは高湿度の環境を好むため、エアコン内部を乾燥させてカビを予防します。
エアコン内部を乾燥してくれる「内部クリーン機能」や「内部乾燥運転」などが搭載されているエアコンなら、そちらを活用しましょう。
このような機能がないエアコンの場合は、冷房や除湿運転の後に1時間程度送風運転をして、エアコン内部を乾かしてください。
カビ予防③部屋の掃除と換気
エアコン内部にホコリなどの汚れを取り込まないために、部屋の掃除や換気をして、室内の空気をキレイな状態にしておくこともカビ予防につながります。
たまったホコリの中にカビが生息していることもあるため、室内にもホコリをためないよう定期的に掃除と換気をするように心がけましょう。
おそうじ本舗のエアコンクリーニングは完全分解洗浄でカビを徹底除去
エアコンからカビ臭いニオイがする、吹き出し口からエアコンの中をのぞいたら黒い点々がたくさん見えるなど、すでにエアコン内部にカビが繁殖しているサインは出ていませんか?
一度カビが繁殖してしまうと、エアコンを分解して掃除しなければカビを取り除くことはできません。
おそうじ本舗のエアコンクリーニングなら、エアコン洗浄の妨げになるパーツを全て取り外して掃除する「完全分解洗浄」で、エアコンの奥のカビや汚れも徹底的にキレイにできます。
取り外したパーツも全て洗浄してから元通りに組み立てるので、一般的なエアコンクリーニングでは取りきれない汚れもスッキリ除去することが可能です。
さらに、クリーニング後にはオリジナルの防カビ剤(※)で仕上げるので、キレイが長続きします。
「まだカビは繁殖していないから大丈夫」と考えている方も、長年エアコンを使っているなら、ぜひ一度エアコンクリーニングを検討してみてください。
エアコンを分解してみると、気がつかないうちに内部がカビだらけになっていたというケースは少なくありません。
定期的なフィルター掃除などのお手入れとあわせて、一年に1回を目安にエアコンクリーニングを行えば、安心して快適にエアコンを使えるでしょう。
※オリジナル防カビ剤は全てのカビを抑制するものではありません。
この記事についてのお問い合わせ
メディア関連の取材やコンテンツ使用のご相談は、下記のフォームからお問い合わせください。
この記事の監修者
ハウスクリーニング商品開発尾崎 真
おそうじ本舗の商品・サービス開発責任者を務め、国家資格であるハウスクリーニング技能士。 住まいのお掃除のコツや、暮らしに関するテクニックなど、お家で役立つ情報について満足していただける内容の改修を行っています。
おそうじ本舗 自分でできるお掃除術 監修者について

